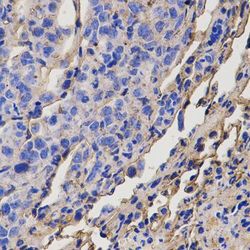

Antibody data
- Antibody Data
- Antigen structure
- References [0]
- Comments [0]
- Validations
- Western blot [1]
- Immunocytochemistry [1]
- Immunohistochemistry [1]
Submit
Validation data
Reference
Comment
Report error
- Product number
- GTX54003 - Provider product page

- Provider
- GeneTex
- Product name
- Dopamine Receptor D5 antibody
- Antibody type
- Polyclonal
- Reactivity
- Human, Mouse
- Host
- Rabbit
No comments: Submit comment
Supportive validation
- Submitted by
- GeneTex (provider)
- Main image

- Experimental details
- WB analysis of mouse brain extract using Dopamine Receptor D5 antibody.
Supportive validation
- Submitted by
- GeneTex (provider)
- Main image

- Experimental details
- ICC/IF analysis of HeLa cells using Dopamine Receptor D5 antibody (green) and DAPI (blue).
Supportive validation
- Submitted by
- GeneTex (provider)
- Main image
- Experimental details
- IHC-P analysis of mouse lung metastasis tissue using Dopamine Receptor D5 antibody at a dilution of 1:200.